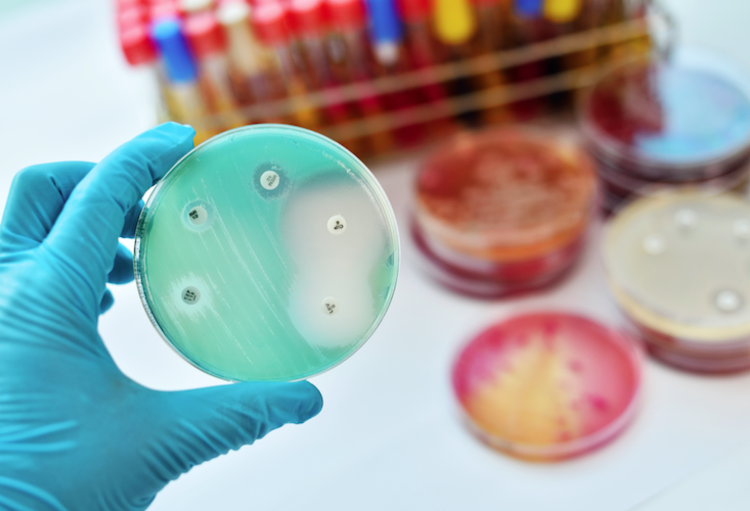

Dans un vibrant appel à l'action, les médecins spécialistes tirent la sonnette d'alarme face à la crise croissante de la résistance aux antimicrobiens (RAM). Le moment choisi n'est pas une coïncidence. Bruxelles accueille actuellement, sous la présidence belge de l'UE, une conférence visant à faire progresser – au niveau mondial – la lutte contre les infections nosocomiales, entre autres. «Malheureusement, nos décideurs politiques font preuve d'un manque d'urgence criant dans ce domaine», peut-on lire.
Les spécialistes, experts en maladies infectieuses cliniques et en microbiologie médicale, soulignent que malgré la gravité de la pandémie de RAM, la réponse des décideurs politiques belges reste inadéquate. C'est pourquoi l'Association professionnelle belge des Médecins spécialistes en Infectiologie clinique (BBKI/UBIC), la Société belge d'Infectiologie et de Microbiologie Clinique (BVIKM/SBIMC) et le groupe de travail sur la microbiologie médicale de l'Association professionnelle belge des Médecins spécialistes en Biologie clinique tirent la sonnette d'alarme.
Sous-financement chronique
«Il y a un sous-financement chronique et un manque de vision à long terme. En conséquence, nos disciplines médicales peuvent difficilement se développer. Dans une minorité des 103 hôpitaux belges, les infectiologues cliniques sont actifs, par exemple, dans la lutte pour une meilleure utilisation des antibiotiques. La cohérence politique est insuffisante, les activités cruciales de gestion des antimicrobiens ne sont pas entièrement financées et l'élaboration de lignes directrices nationales en matière d'antimicrobiens, qui sont importantes pour tous les hôpitaux et les cabinets de médecine générale, n'a pas été soutenue depuis des années. Malgré de nombreuses promesses.»
Tout cela conduit à une stagnation inquiétante dans la lutte contre la RAM. Les Centres européens de contrôle des maladies (European Centers for Disease Control, ECDC) ont déjà averti dans leur rapport de 2017 que notre pays est à la traîne dans la lutte contre la RAM, mettant la santé publique en danger
«Il manque un meilleur cadre dans lequel les hôpitaux peuvent consacrer davantage d'efforts à la prévention des infections, à la surveillance, à l'utilisation correcte des antibiotiques et à la gestion rationnelle des épidémies, avec également le soutien des soins de première ligne. Les récentes pandémies et épidémies ont prouvé l'importance de notre expertise dans ce domaine.»
Les questions qui se posent aux décideurs politiques sont claires:
«Tout d'abord, nous avons besoin d'une reconnaissance officielle et d'un soutien pour nos services. C'est absolument nécessaire pour survivre en tant que discipline médicale dans le paysage hospitalier. Deuxièmement, il faut un financement durable pour les lignes directrices nationales sur les antimicrobiens dans les hôpitaux, telles que le Guide interdisciplinaire des maladies infectieuses (IGGI). Et troisièmement, nous avons besoin d'un cadre de développement politique inclusif pour la RAM et les maladies infectieuses, en recherchant un partenariat complet avec les associations scientifiques et professionnelles afin de mettre en œuvre des stratégies efficaces.»

Derniers commentaires
Bénédicte MATHYS
09 mai 2024Pas que le bétail.
Toute la filière agro alimentaire.
Patrick COLART
09 mai 2024On ne parle pas suffisamment des quantités astronomiques d'antibiotiques utilisées toujours sans frein dans l'élevage du bétail. Il est pourtant fort probable que ces antibiotiques se retrouvent dans l'alimentation humaine et participent donc au développement d'une résistance croissante de nos flores microbiennes à ces agents anti-infectieux. Les médecins ne sont probablement pas les seuls à aggraver la résistance aux antibiotiques par leurs prescriptions...
Dr Patrick Colart